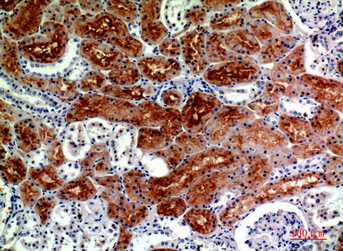

-
中文名稱:DROSHA兔多克隆抗體
-
貨號:CSB-PA352154
-
規格:¥1090
-
圖片:
-
Western blot analysis of SH-SY5Y K562 HELA using RNase III Drosha antibody. Antibody was diluted at 1:1000. Secondary antibody was diluted at 1:20000
-
Immunohistochemical analysis of paraffin-embedded human-brain, antibody was diluted at 1:200
-
Immunohistochemical analysis of paraffin-embedded human-kidney, antibody was diluted at 1:200
-
Immunohistochemical analysis of paraffin-embedded human-kidney, antibody was diluted at 1:200
-
-
其他:
產品詳情
-
Uniprot No.:
-
基因名:DROSHA
-
別名:DROSHA antibody; Drosha double stranded RNA specific endoribonuclease antibody; Drosha ribonuclease type III antibody; Etohi2 antibody; HSA242976 antibody; Nuclear RNase III Drosha antibody; p241 antibody; Protein Drosha antibody; Putative protein p241 which interacts with transcription factor Sp1 antibody; Putative ribonuclease III antibody; RANSE3L antibody; Ribonuclease 3 antibody; Ribonuclease III antibody; Ribonuclease III nuclear antibody; Ribonuclease type III nuclear antibody; RibonucleaseIII antibody; RN 3 antibody; RN3 antibody; RNase 3 antibody; RNase III antibody; RNase3 antibody; RNASE3L antibody; RNaseIII antibody; RNASEN antibody; RNC_HUMAN antibody
-
宿主:Rabbit
-
反應種屬:Human,Mouse
-
免疫原:Synthesized peptide derived from the Internal region of Human RNase III Drosha.
-
免疫原種屬:Homo sapiens (Human)
-
標記方式:Non-conjugated
-
純化方式:The antibody was affinity-purified from rabbit antiserum by affinity-chromatography using epitope-specific immunogen.
-
濃度:It differs from different batches. Please contact us to confirm it.
-
保存緩沖液:Liquid in PBS containing 50% glycerol, 0.5% BSA and 0.02% sodium azide.
-
產品提供形式:Liquid
-
應用范圍:WB, IHC, ELISA
-
推薦稀釋比:
Application Recommended Dilution WB 1:500-1:2000 IHC 1:100-1:300 ELISA 1:10000 -
Protocols:
-
儲存條件:Upon receipt, store at -20°C or -80°C. Avoid repeated freeze.
-
貨期:Basically, we can dispatch the products out in 1-3 working days after receiving your orders. Delivery time maybe differs from different purchasing way or location, please kindly consult your local distributors for specific delivery time.
-
用途:For Research Use Only. Not for use in diagnostic or therapeutic procedures.
相關產品
靶點詳情
-
功能:Ribonuclease III double-stranded (ds) RNA-specific endoribonuclease that is involved in the initial step of microRNA (miRNA) biogenesis. Component of the microprocessor complex that is required to process primary miRNA transcripts (pri-miRNAs) to release precursor miRNA (pre-miRNA) in the nucleus. Within the microprocessor complex, DROSHA cleaves the 3' and 5' strands of a stem-loop in pri-miRNAs (processing center 11 bp from the dsRNA-ssRNA junction) to release hairpin-shaped pre-miRNAs that are subsequently cut by the cytoplasmic DICER to generate mature miRNAs. Involved also in pre-rRNA processing. Cleaves double-strand RNA and does not cleave single-strand RNA. Involved in the formation of GW bodies.
-
基因功能參考文獻:
- analysis of the recurrent homozygous deletion of DROSHA and microduplication of PDE4DIP in pineoblastoma PMID: 30030436
- Our study provides mechanistic insights into the function of miR-128-3p as a key regulator of the malignant phenotype of lung cancer cells...and in particular it highlights a role for Drosha in non-small-cell lung cancer cells migration PMID: 29236960
- Different genotypes frequency of DROSHA (rs10719, rs642321 and rs2291102) were determined by sequencing method in 385 infertile men and 120 fertile controls. No significant differences were seen between cases and controls for DROSHA expression. PMID: 29892896
- The Drosha rs10719TC and CC genotypes were associated with PE risk. The CC-GG combined genotype and C-G haplotype of Drosha rs10719 and rs6877842 polymorphisms may increase PE susceptibility. PMID: 29157048
- Primary microRNA transcripts (pri-miRs) are cleaved by Microprocessor, a complex containing the RNase Drosha and its partner protein, DGCR8. Although DGCR8 is known to bind heme, the molecular role of heme in pri-miR processing is unknown. Here we show that heme is critical for Microprocessor to process pri-miRs with high fidelity. PMID: 29170488
- Taken together, our results provided the potential evidence that rs10719 and rs493760 might contribute to the risk of CL/P and suggested potential genetic basis and mechanisms of CL/P. PMID: 28833944
- It has been reported that the gene encoding human DROSHA also encodes a potential miRNA and that this miRNA may act upon, at least, one of DROSHA transcripts. PMID: 28665784
- Depletion of drosha ribonuclease III (Drosha) significantly reduces DNA repair by both homologous recombination (HR) and non-homologous end joining (NHEJ). PMID: 29416038
- Increased Drosha expression was found in chronic lymphocytic leukemia patients without chromosomal deletions. PMID: 28388279
- point mutations in the RNaseIIIb domain of Drosha implicated in Wilms tumors differentially affected cleavage of the 5' and 3' strands of pri-miRNAs in vitro. PMID: 29109067
- Overexpression of LAMC2 and knockdown of CD82 markedly promoted GC cell invasion and activated EGFR/ERK1/2-MMP7 signaling via upregulation of the expression of phosphorylated (p)-EGFR, p-ERK1/2 and MMP7. PMID: 28252644
- A significant association was observed between 2 candidate genes and AD, TARBP2 rs784567 genotype and AD (chi=6.292, P=0.043), and a trend for RNASEN rs10719 genotype (chi=4.528, P=0.104) and allele (P=0.035). On controlling for Age, we found that for the TARBP2-RNASEN association with AD the age variation was a risk factor for AD risk (P<0.001; OR=1.104; 95% CI, 1.059-1.151) PMID: 26796812
- BRG1 and SMARCAL1, members of the ATP-dependent chromatin remodelling family, are shown to co-regulate the transcription of DROSHA, DGCR8, and DICER in response to double-strand DNA breaks PMID: 28716689
- Mechanistic dissection reveals that NEAT1 broadly interacts with the NONO-PSF heterodimer as well as many other RNA-binding proteins and that multiple RNA segments in NEAT1, including a 'pseudo pri-miRNA' near its 3' end, help attract the Drosha-DGCR8 Microprocessor. PMID: 28846091
- Results show that Mammalian DROSHA genes have evolved a conserved hairpin structure spanning a specific exon-intron junction serving as a substrate for the microprocessor in human but not in murine cells. This hairpin element decides whether the overlapping exon is alternatively or constitutively spliced. Also, DROSHA promotes skipping of the overlapping exon in human cells independently of its cleavage function. PMID: 28400409
- Report DROSHAnumerous processing sites on primary microRNAs and noncanonical substrates which may serve as cis-elements for DROSHA-mediated gene regulation. PMID: 28431232
- Knockdown of Drosha, the apoptosis rate of MGC-803 cells was increased, the protein expressions of caspase-3 , caspase-9 and Bax were significantly upregulated and Bcl-2 was downregulated. PMID: 27609577
- The rs417309 and rs1640299 polymorphisms of the DGCR8 gene as well as rs6877842 of the DROSHA gene might be associated with a risk of laryngeal cancer occurrence in the Polish population. PMID: 28155978
- miR-27b mimics, DROSHA siRNA, and miR-27b inhibitors to verify the negative regulatory relationship between MiR-27b and DROSHA. The presence of rs10719 disrupted the interaction between miR-27b and DROSHA, which might be the underlying mechanism of the observation that rs10719 is significantly associated with risk of primary hypertension. PMID: 28214904
- Drosha and DGRC8 were significantly downregulated in healthy-appearing perilesional skin from hidradenitis suppurativa patients compared to healthy controls. PMID: 26917346
- Mutations of DROSHA gene underlie Wilms tumor recurrences. PMID: 26802027
- An essential role of DROSHA in the canonical miRNA pathway PMID: 26976605
- Gradual loss of cytoplasmic Drosha was accompanied by tumor progression in both gastric cancer tissues and cell lines, and was inversely associated with tumor volume (P = 0.002), tumor grade (P < 0.001), tumor stage (P = 0.018), and distant metastasis PMID: 26694172
- DGCR8 and Drosha assemble into a heterotrimeric complex on RNA, comprising two DGCR8 molecules and one Drosha molecule. PMID: 26683315
- Study reports the X-ray structure of DROSHA in complex with the C-terminal helix of DGCR8; DROSHA contains two DGCR8-binding sites, one on each RNase III domain (RIIID), which mediate the assembly of Microprocessor; overall structure of DROSHA is surprisingly similar to that of Dicer despite no sequence homology apart from the C-terminal part. PMID: 26748718
- Variations in DROSHA rs10719 of Korean patients are significantly associated with their risk of colorectal cancer. PMID: 26147304
- Drosha expression was reduced gradually with the degrading histological differentiation of gastric adenocarcinoma, and the knock-down of Drosha expression could promote gastric adenocarcinoma cell invasion. PMID: 26522361
- data underscore the pivotal role of the miRNA biogenesis pathway in WT tumorigenesis, particularly the major miRNA-processing gene DROSHA PMID: 24909261
- Drosha is upregulated in gestational diabetes. PMID: 25295740
- Together with a 23-amino acid peptide from DGCR8, DROSHA constitutes a minimal functional core. DROSHA serves as a "ruler" by measuring 11 bp from the basal ssRNA-dsRNA junction. DGCR8 interacts with the stem and apical elements through its dsRNA-binding domains and RNA-binding heme domain, respectively, allowing efficient and accurate processing. PMID: 26027739
- DROSHA RNase IIIB mutations globally inhibit miRNA biogenesis through a dominant-negative mechanism in Wilms tumors. PMID: 25190313
- Drosha protein was identified as a new component of dipeptide-repeat aggregates in frontotemporal lobar degeneration and tauopathy. PMID: 25756586
- p38 MAPK directly phosphorylates Drosha at its N terminus promoting its nuclear export and degradation. PMID: 25699712
- To inhibit the expression of Drosha. PMID: 25058539
- Low Drosha expression is associated with invasive breast carcinoma. PMID: 24574065
- DROSHA rs10719T>C polymorphism may be associated with bladder cancer risk in a Chinese population, and hsa-miR-27b can influence the expression of DROSHA protein by binding with 3'UTR PMID: 24312312
- conclude that Drosha can function like a splicing enhancer and promote exon inclusion. Our results reveal a new mechanism of alternative splicing regulation involving a cleavage-independent role for Drosha in splicing PMID: 24786770
- The involvement of E2F1-dependent DROSHA activation in pri-miRNA processing under DNA damage stress will provide further insight into the regulation of miRNA biosynthesis. PMID: 24909689
- Drosha regulates nascent gene transcription trhough interaction with CBP80 and RNA PolII. PMID: 24360955
- The pri-miRNA stem, defined by internal and flanking structural elements, guides the binding position of Drosha-DGCR8, which consequently determines the cleavage site. PMID: 24854622
- The Microprocessor complex of Drosha and DGCR8 proteins, which is responsible for the processing of the primary transcripts during the generation of microRNAs, destabilizes the mRNA of Aurora kinase B. PMID: 24589731
- Change in Drosha expression can be a biologically relevant mechanism by which eukaryotic cells control miRNA profiles PMID: 24677349
- Acetylation of Drosha on those N-terminal lysine sites prevents Drosha ubiquitination, thereby preventing its degradation. PMID: 24009686
- Our results suggest that Drosha affects the biological activity of cervical cancer cells by regulating the expression of numerous tumour-associated proteins. PMID: 23969986
- results indicate a block of miRNA maturation at the DROSHA processing step PMID: 23974981
- If the distances are not optimal, Drosha tends to cleave at multiple sites, which can, in turn, generate multiple 5' isomiRs. PMID: 24297910
- Our results demonstrate a reduced nuclear expression of DROSHA in melanoma PMID: 23370771
- RNase III enzyme Drosha and the double-stranded RNA-binding protein DGCR8 binds and regulates a large variety of cellular RNAs PMID: 23863141
- Drosha protein potentially plays an important role in breast cancer progression. PMID: 23225145
- miRNA regulatory effect is a heritable trait in humans; a polymorphism of the DROSHA gene contributes to the observed inter-individual differences. PMID: 23272639
顯示更多
收起更多
-
亞細胞定位:Nucleus. Nucleus, nucleolus.
-
蛋白家族:Ribonuclease III family
-
組織特異性:Ubiquitous.
-
數據庫鏈接:
Most popular with customers
-
-
YWHAB Recombinant Monoclonal Antibody
Applications: ELISA, WB, IHC, IF, FC
Species Reactivity: Human, Mouse, Rat
-
-
-
-
-
-